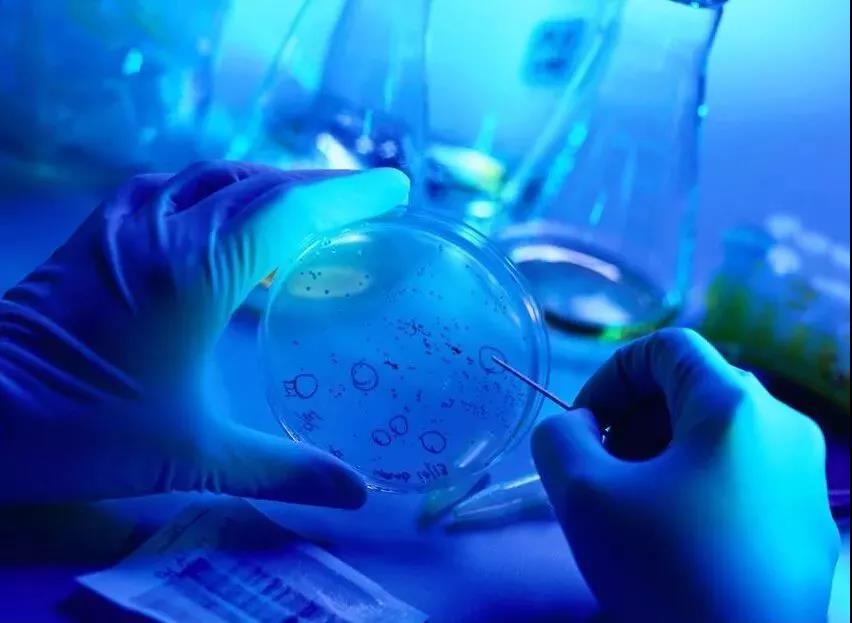
4.jpg

目前,肺癌主要的治疗方式有外科手术、放化疗、靶向治疗、介入治疗、生物免疫治疗以及中医中药治疗等;此外每年都会有更多的临床新数据新证据新进展,包括微创外科手术、化疗药物,靶向治疗,放射治疗,免疫治疗等。
外科手术
早期癌症主要治疗手段

19世纪,麻醉技术及无菌技术等逐渐成熟,手术成为治疗癌症的主要方式。能早期就得到诊断,手术仍然是切除原发病灶的有效方法。根据国际抗癌联盟统计,超过70%的非小细胞癌患者在确诊时已经是肺癌晚期或局部晚期,目前只有不到30%的患者有机会和条件接受手术治疗。
放疗
定位组织准确,剂量控制不准副作用大

放疗是一种用放射线来杀伤肿瘤细胞的局部治疗手段,大多数疗效确切,能够显著巩固化疗或手术的疗效,延长肺癌患者的生存期。相比化疗来说,放疗定位准确,正常组织损伤小。对射线照到的部位会产生一定的副作用。
一般2公分以内的范围,会出现全身乏力、食欲下降等不需要处理的轻微副反应;中晚期、癌扩散范围较大的病人,照射射线剂量提到很高时,会产生像"地震"的副作用,根据部位不同可能会产生脱发、皮肤出现红斑、瘙痒、脱屑、黏膜溃疡、影响进食、恶心、呕吐等。
但是局部治疗也有局限性,因为照射范围小,不能保证照射区域的完整。所以放疗经常配合手术、化疗一起实施,这种综合治疗方案,需要医生对病人情况准确得评估判断才能有效。
内科治疗
以靶向治疗为主,多种疗法结合为辅

单一的放化疗的方法像是"蒙着眼睛打靶",命中率低。抗肿瘤药物的进展包括靶向药物的出现,则大大提高了治疗的精确度及有效性。靶向治疗的前提是要找到正确靶点,一旦明确了致癌的分子靶点,人体内的癌细胞就好像是带有标志的目标,更容易被狙击手找到,一枪毙命。
免疫疗法
免疫疗法将成为主流抗癌疗法
尽管放疗、手术、化学药物治疗还有靶向治疗仍然是肺癌治疗最主要的手段,但是具体的治疗方式要根据病人的肿瘤分期以及体质确定,治疗的效果也不能一概而论,主要是取决于病人身体素质,以及对治疗的耐受性。
在2015年芝加哥召开的ASCO会议上,公布了抑制剂(抗PD-1药物)的详细数据:其对582位患者进行临床试验,发现使用其他标准化的治疗手段,Ⅳ期肺癌患者的生存期为9.4个月,而使用了抑制剂(抗PD-1药物)进行免疫治疗后,患者的平均生存期提高到12.2个月,最长的生存期为19.4个月,是常规标准化疗法的近2倍。
西班牙马德里Doce de Octubre医院的Luis Paz-Ares博士表示这项研究在寻找肺癌新疗法上具有里程碑的作用,在继化疗对患者无效之后,使用免疫疗法较高的生存期令医生们也很惊讶。
英国癌症研究学会认为,对免疫系统的研究将是癌症新疗法中重要的一部分,同时建议病人在治疗之前要尽量的提升免疫力,改善体质,并要增强身体对治疗的耐受性,以确保治疗的效果。
据统计,在2016年世界卫生组织对各个国家医疗水平的排名中,日本排名第一,日本在癌症领域的研究和治疗都走在世界前列,已经是效果最好的国家之一。
日本细胞免疫治疗技术获得了大量国际技术专利。整个培养过程需按照GMP(Good Manufacturing Practice)标准,在无菌管理的情况下进行培养,质量管理极度严格。日本培养增殖并活化的免疫细胞,在向患者回注时能确保97%的细胞存活率,从而达到治疗期待的效果。
免疫细胞治疗,助力癌症康复的“新武器”

20岁是人体免疫力的巅峰,无论是免疫细胞数量,还是免疫细胞活性,都处于巅峰状态。但随着年龄增长,能保护我们不受疾病困扰的免疫细胞逐渐退化。
对免疫细胞进行高品质的激活和扩增后,重新输回至人体,此时的免疫细胞功能增强,对受损细胞进行修复与调控,激活休眠细胞功能,增加正常细胞的数量,提高细胞的活性,从而改善细胞的质量,从本源上调整免疫系统的平衡。